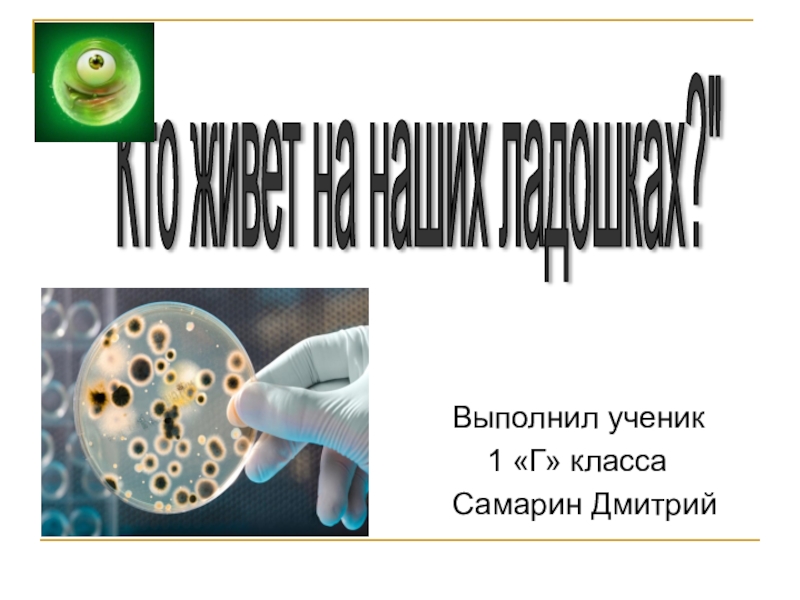

наших ладошках?"
- Главная
- Разное
- Образование
- Спорт
- Естествознание
- Природоведение
- Религиоведение
- Французский язык
- Черчение
- Английский язык
- Астрономия
- Алгебра
- Биология
- География
- Геометрия
- Детские презентации
- Информатика
- История
- Литература
- Математика
- Музыка
- МХК
- Немецкий язык
- ОБЖ
- Обществознание
- Окружающий мир
- Педагогика
- Русский язык
- Технология
- Физика
- Философия
- Химия
- Шаблоны, фоны, картинки для презентаций
- Экология
- Экономика
Презентация, доклад исследовательского проекта Кто живет на наших ладошках?
Содержание
- 1. Презентация исследовательского проекта Кто живет на наших ладошках?
- 2. Кто живет на наших ладошках?
- 3. Как выглядят микробы под микроскоп?
- 4. Слайд 4
- 5. Микробы бывают:
- 6. Слайд 6
- 7. Слайд 7
- 8. Как избавиться от вредных микробов?
- 9. Средства гигиены
- 10. Слайд 10
- 11. Слайд 11
- 12. Спасибо за внимание
Кто живет на наших ладошках? Во время прогулки, в транспорте, во время игры с песком, с игрушками, вместе с пылью и грязью на наши руки попадают микробы, вирусы.
Слайд 2Кто живет на наших ладошках?
Во
время прогулки, в транспорте, во время игры с песком, с игрушками, вместе с пылью и грязью на наши руки попадают микробы, вирусы.
Это крохотные, маленькие пылинки, их даже не видно на наших ладонях. Но они очень опасны – это возбудители болезней.
Это крохотные, маленькие пылинки, их даже не видно на наших ладонях. Но они очень опасны – это возбудители болезней.
Слайд 8Как избавиться от вредных микробов?
МОЙТЕ ЧАЩЕ РУКИ!
Руки рекомендуется тщательно мыть:
1. После туалета.
2. После общения с животными,
3. Перед приготовлением пищи и перед едой,
4. После улицы,
5. При уборки помещения и во всех случаях, когда руки загрязнены…
Тщательно следите за своими руками.
Ногти должны быть чистыми и коротко подстриженными.
Регулярное мытье рук и уход за ногтями защитит от многих болезней.
Не забывайте о ногах. Они часто потеют,
появляется неприятный запах, поэтому их также надо мыть ежедневно